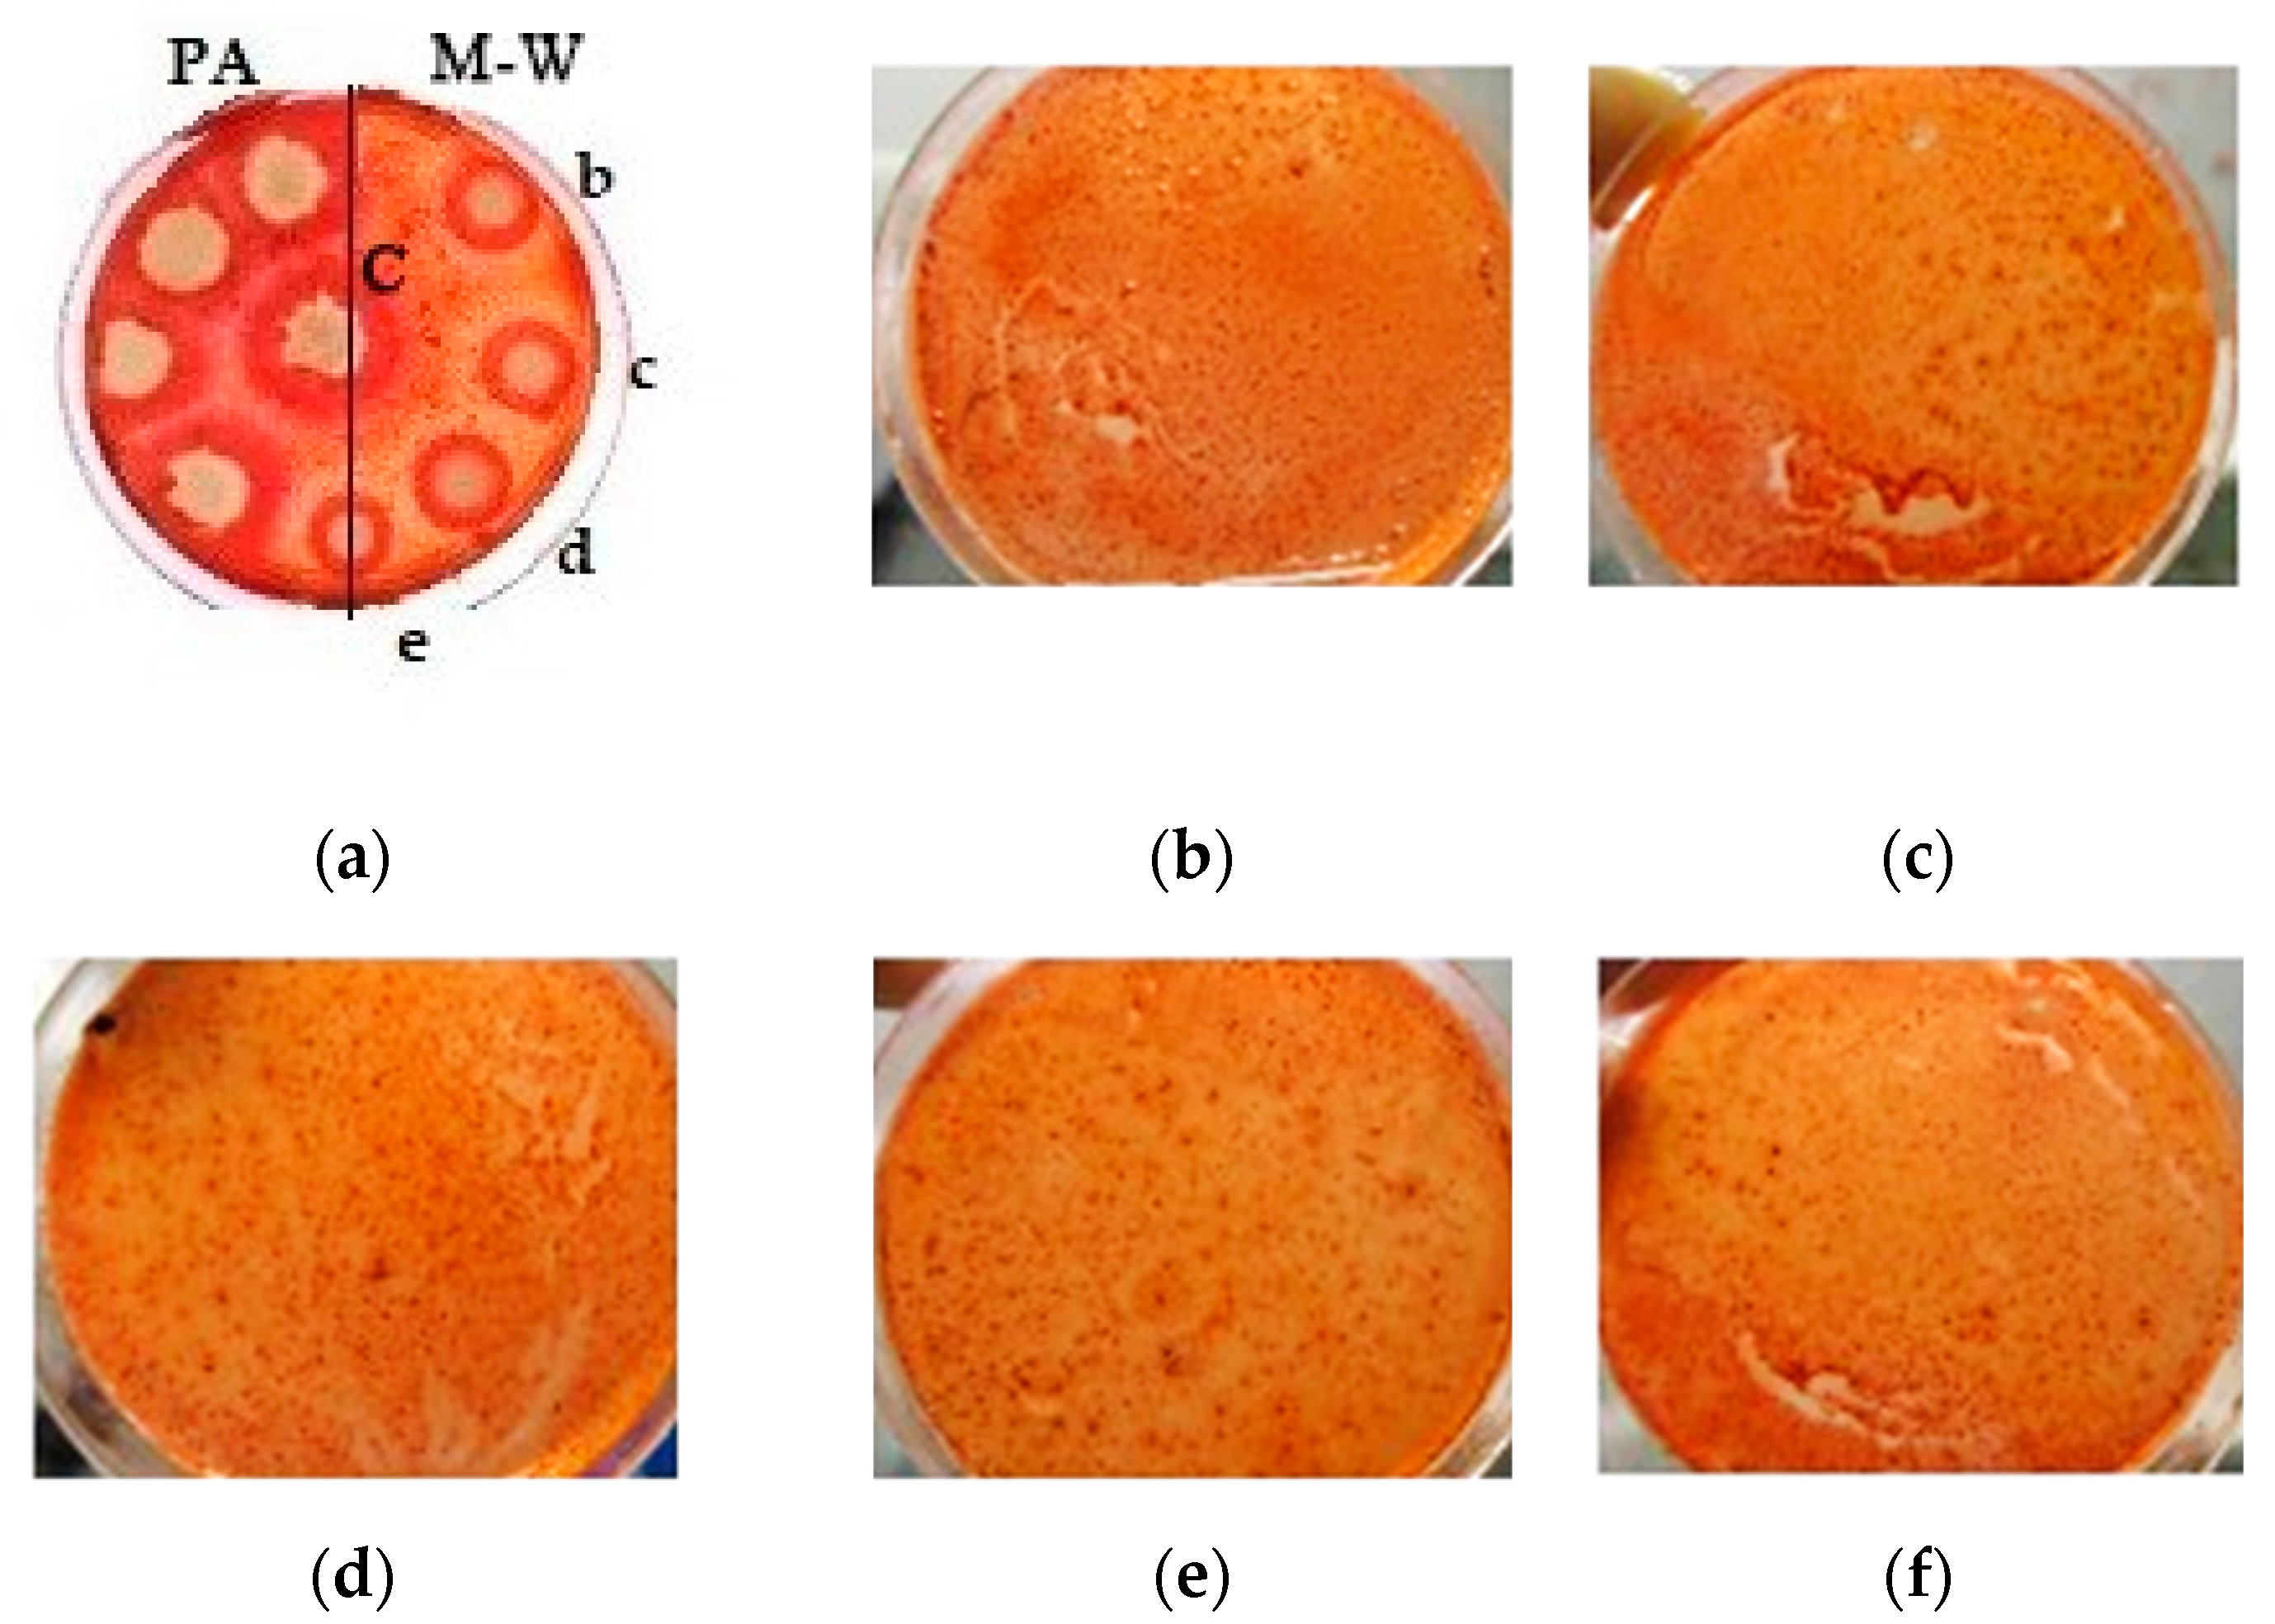
Processes 09 01360 g005

1. Introduction
The development of efficient methods for the production of biofuels is becoming increasingly important, due to the depletion of fossil fuels and the environmental conditions that are associated with their extraction. Possessing environmental and economic advantages, bioethanol is able to compete in the global fuel market. It can be used alone or as an additive to gasoline [
1].
Bioenergy production has significantly increased in the recent decades, as part of the transition to a carbon-neutral energy system, and its growth is expected to continue, particularly in the form of biofuels such as bioethanol. The global market is forecasted to increase the share of bioethanol production from the current 2% to 27% by 2050 [
2].
Bioethanol production has been strongly supported by the United States and Brazil, which are the leading producing countries [
3]. Several patents that are devoted to methods of converting cellulosic material into ethanol by fermentation (RU 2432368, RU 2456394, RU 2529371, and RU 2593724) and GOST R 33872-2016 [
4,
5,
6], are registered in Russia. However, Russian biofuel production is only inthe pilot stage [
7].
Cellulosic biomass is attractive as a source of raw materials, due to its availability and renewability [
3,
8,
9,
10,
11]. The study [
12] showed that microorganisms with visual differences in the morphology and growth of colonies (including bacteria, yeast, and filamentous fungi), were found in mangroves in Brazil.Metagenomic sequencing data showed the predominance of the following bacterial types:
Proteobacteria (57.8%),
Firmicutes (12.3%), and
Actinobacteria (8.4%). It was found that these microorganisms produce a large number of enzymes that are involved in the degradation of polycyclic aromatic compounds. Specific sequences that are involved in cellulolytic degradation, belonging to cellulases, hemicellulases, carbohydrate-binding domains, dockerins, and cohesins, were identified. It became possible to isolate cultivated fungi and bacteria that are associated with biomass decomposition and the potential for use in biofuel production. These results showed that cellulosolytic microorganisms that are present in mangroves possess all the basic molecular tools for building the cellulosome, which is necessary for the efficient degradation of cellulosic material and the release of sugar.
To provide an economically viable process for its bioconversion into bioethanol, it is necessary to achieve effective splitting of polymeric lignocellulosic raw materials into monomeric sugars, which are further fermented by microorganisms (yeast or bacteria). The composition and concentration of sugars in the lignocellulose hydrolysate vary depending on the composition of the raw material and the processing method. Other important factors of alcoholic fermentation include the selection and preparation of the substrate, the selection and adaptation of the microorganisms, and the process conditions [
1].
Enzymatic hydrolysis is conducted using the cellulase enzyme complex. Endoglucanases rapidly and randomly break down the internal cellulose sites. The products of this reaction serve as a substrate for the action of exoglucanases, which mainly release cellobiose by breaking down oligosaccharides. Enzymatic hydrolysis occurs under the synergistic action of the following three main classes of cellulases: endoglucanase, exoglucanase, and β-glucosidase [
13]. The main advantages of enzymatic hydrolysis include technological accessibility, the high specificity of enzymes, and reduced generation of by-products and inhibitory products. The disadvantages include the high cost of enzyme preparations and the duration of the hydrolysis process (48–72 h). It is important to consider the concentration and structure of the substrate (reaction rate) and enzyme concentration (price/reaction rate ratio) in enzymatic hydrolysis [
14].
The main constraints of the lignocellulosic biomass fermentation are the crystalline structure of cellulose and the formation of a lignin–cellulose complex. High pressure and temperature lead to the destruction of glucose and the formation of reaction by-products [
3].
Fungal amylases are used to hydrolyze carbohydrates, proteins, and other components of soybeans and wheat, into peptides, amino acids, sugars, and other low-molecular-weight compounds [
13,
15]. The study [
13] was carried out to assess the amylase activity of the amylolytic fungi
Aspergillus niger, using cassava waste as a fodder substrate. Fungi were isolated from soil samples and identified as
Aspergillus niger, based on lactophenol cotton blue staining and plating on an appropriate fungal growth medium. The production of
Aspergillus niger amylase was detected by the disappearance of the blue color in the agar medium, with starch around the microbial colonies after incubation. Cassava was used as a substrate for amylase production. Solid-phase fermentation was performed using
Aspergillus niger to obtain amylase. Amylase activity was determined by the following four methods: the DNSA method, dextrinization method, reduction in starch–iodine color intensity, and assay on plates.
Solid-phase fermentation has great potential for the amylase enzyme production by
Aspergillus niger [
16].Hard substrates that are rich in starch, such as rice bran, wheat bran, rye bran, coconut oil cake, ginger cake, and peanut cake, are used.These agro-industrial residues are cheap raw materials for amylase production.It was found that
Aspergillus niger is the best amylase producer.The addition of carbohydrates and nitrogen increased the yield of amylase [
16].
Membrane enzymatic hydrolysis, in comparison with chemical hydrolysis, has significant application potential [
17,
18], due to the higher yield of a low-toxic product, environmental friendliness, complete decomposition of lignocellulosic biomass [
16], high degree of conversion of carbohydrates, absence of toxic waste, greater yield of the target product, and the ability to modify and cultivate microorganisms to obtain significant quantities of high-quality biofuel. Nonetheless, this method requires modernization and adaptation.
Using membranes to extract and reuse cellulase saves energy, reduces the cost of purchasing an enzyme preparation, and shortens the time that is required by the stages of enzymatic hydrolysis [
14]. Membrane filtration is widely used in this process. In this case, the enzyme, while maintaining its relative catalytic activity, recirculates up to 75% of the enzyme and is reused in the process of hydrolysis [
11]. The membranes are made from hollow fibers of cellulose acetate, polysulfone, nylon, and polyethersulfone.
The rigid structure of lignocellulosic biomass prevents the enzymatic hydrolysis of polysaccharides, which prevents the conversion of biomass into bioethanol [
3]. The combined use of several methods in pretreatment (chemical, physical, electrical, and biological) promotes the degradation of lignocellulose, reduces the impermeability of the biomass, and facilitates the access of enzymes to their substrates; however, the processes of the pretreatment of lignocellulosic materials cause an increased formation of undesirable by-products, originating from lignin, which can inhibit the growth of microbes and, consequently, reduce the fermentation yield [
19,
20]. The use of microorganisms helps to avoid many of these difficulties and, in combination with the membrane methods of enzymatic purification, helps to intensify this process.
It is known [
21] that
Aspergillus niger secretes endoglucanase, exoglucanase, andβ-glucosidases (EC 3.2.1.21, EC 3.2.1.4, EC 3.2.1.74), which have many biotechnological and industrial applications. It was found that the purified enzyme with a molecular weight of 116 kDa, forms monomers in the solution, according to the data of native gel electrophoresis, and has a pI value of 4.55, as found for most fungal β-glucosidases. Small-angle X-ray experiments showed that these β-glucosidases have a tadpole-like structure, with an N-terminal catalytic domain and a C-terminal fibronect in III-like domain (FnIII) linked by a long linker peptide (~100 amino acid residues) in an extended conformation. This molecular organization resembles the organization of other cellulases (such as, for example, cellobiohydrolases), which often contain a catalytic domain that is associated with a cellulose-binding module, which mediates their binding to insoluble and polymeric cellulose. The reasons why β-glucosidases from
Aspergillus niger act on small soluble substrates and have the form of a tadpole molecule, are not entirely clear. However, assays with reduced enzymes with various polymeric substrates suggest that these β-glucosidases have little or no ability to bind and adsorb cellulose, xylan, and starch, but have a high lignin affinity. Molecular dynamics simulations have shown that clusters of residues that are located in the C-terminal domain of FnIII, strongly interact with lignin fragments. Modeling has shown that numerous arginine residues, scattered over the surface of FnIII, play an essential role in the interaction with lignin through the π-stacking of cations with lignin aromatic rings. These results indicate that the C-terminal domain of FnIII can act to immobilize the enzyme on the cell wall and prevent the unproductive binding of cellulase to lignin [
21].
Aspergillus niger fungus produces a significant amount of cellulase and protease activity in its extracellular environment. The maturation rate of fungi during the takeover of large territories is unique (within three days, intensive sporulation occurs). This study is aimed at experimentally selecting the optimal process for the enzymatic hydrolysis of cellulose-containing raw materials, using Aspergillus niger exposed to ultraviolet (UV) radiation and chemical treatments.
2. Materials and Methods
2.1. Microorganisms
Aspergillus niger F-1270 was acquired from the collection of microorganisms of the Federal Institution “State Research Institute of Genetics and Selection of Industrial Microorganisms of the National Research Center” Kurchatov Institute (Moscow, Russia). The recommended cultivation conditions were as follows: temperature of 26 °C, and a malt-peptone agar medium (malt extract 30 g/L, peptone 1 g/L, agar 20 g/L). The culture medium was sterilized at 121 °C for 20 min. The cultivation was carried out by the quadrant or the thinning streak methods on Petri dishes, in test tubes with a cotton and gauze plug. The passage of microscopic fungi was carried out with a bacteriological loop. In addition to the recommended medium, we used the Czapek–Dox and the Mandels–Weber mineral nutrient media to stimulate cellulolytic activity [
18].
Potato agar medium (potato extract/dried and milled potato waste 4 g/L, agar–agar 15 g/L, pH 5) was used to stimulate starch-degrading activity. The media were used for modifications with/without added cellulose and with/without added glucose. Malt-peptone agar was used to disperse microorganisms.
At the stage of the exposure to mutagenic factors, these media were used with the addition of glucose at a concentration of 1 g/L. The media were sterilized by autoclaving at 121 °C for 20 min. A KH2PO4 solution and solution of trace elements (FeSO4·7H2O 5.0 mg/L, MnSO4·7H2O 1.6 mg/L, ZnSO4·7H2O 1.4 mg/L, CoCl2·6H2O 20 mg/L) were prepared and sterilized separately, and the combination with the stock solution was carried out after cooling solutions to room temperature.
The medium used for preparing a spore suspension and enzymatic hydrolysis contained the following (g/L): 0.3 urea, 1.4 (NH4)2SO4, 2.0 KH2PO4, 0.4 CaCl2·2H2O, 0.3 MgSO4·7H2O, 1.0 peptone, 0.2 Tween 80, 0.005 FeSO4·7H2O, 0.0016 MnSO4·7H2O, 0.0014 ZnSO4·7H2O, 0.02 CoCl2·6H2O, 10.0 cellulose; pH 5.
As a control of cellulolytic activity, we used the “Cellulase Ultra” enzyme preparation from
Trichoderma reeseii (Sibbiopharm, Berdsk, Russia), a widespread cellulase-producing culture [
22], which can be used as a reference for studying the cellulase production of
Aspergillus niger. This preparation hydrolyzes β-1,4-glycosidic bonds with an activity of 2500 U per 1 g of enzyme at working ranges of temperatures and pH between 30 to 65 °C and pH 2–7, respectively (optimum at 50–60 °C and pH 4.0–5.5).To prepare the stock solution of the enzyme preparation (control 3), 10 mL (with an accuracy of 0.2 μL) of the preparation was suspended in a small amount of distilled water (up to 50 cm
3) on a magnetic stirrer for 15 min. The suspension was quantitatively transferred into a volumetric flask with a capacity of 200 cm
3 and the volume was brought up to the mark with distilled water. The resulting suspension was centrifuged at 7000 rpm for 15 min. The supernatant was used for analysis.
2.2. Characterization and Pretreatment of Raw Materials
The cellulose of miscanthus (
Miscanthus sinensis Andersson) was used as a substrate for enzymatic hydrolysis. The cellulose of alder chips was used as the primary raw material, and starch and cellulose-containing household waste (potato and bread) were used as secondary raw materials. Miscanthus cellulose is a natural polysaccharide built from anhydro-D-glucopyranose units interconnected with a β-glycosidic bond, with a degree of polymerization (the number of elementary units in a cellulose macromolecule) of 15–20 thousand. The chemical composition of cellulose obtained from miscanthus included α-cellulose 89.4%, ash content 0.34%, acid-insoluble lignin 1.45%, pentosans 9.4%; the crystallinity index was 0.6. Alder chip cellulose is a natural cellulose, high-molecular-weight linear polysaccharide, poly-1.4-β-D-glucopyranosyl-D-glucopyranose with a degree of polymerization from 2000 to 26,000. The average degree of polymerization of alder chip cellulose is 5000–10,000. The chemical composition of cellulose obtained from miscanthus included α-cellulose 88.4%, ash content 0.04%, lignin 0.44%, pentosans 6.0%; the crystallinity index was 0.66. Cellobiose disaccharide is the main structural element that is repeated in the polysaccharide macromolecule. Cellulose-containing waste includes the following: α-cellulose 73.7–77.0%, ash content 0.03%, residual amount of lignin 3.7%, pentosans 9–16%, resins and fats 0.04%; the viscosity of cellulose solutions is 31.0 mPa·s, the crystallinity index is 0.56% [
23,
24].
The secondary raw materials were not additionally pretreated. Starch-containing raw materials were used to advance knowledge of the Aspergillus niger activity against potato starch. Filter paper (blue ribbon filter) was used to determine the cellulolytic activity of microorganisms.
The primary raw material underwent alkaline and acid delignifications. Delignification was performed under hydrolysis conditions with sodium hydroxide solution, namely, 10 g of dry biomass of miscanthus was placed in a two-neck round-bottom flask with a magnetic stirrer, reflux condenser, and thermometer. Water was added to the biomass in a ratio of 10:1, and 4 g of NaOH was added with stirring. The mixture was stirred for 4 h at 75 °C. In the case of acid hydrolysis, trifluoroacetic acid (30 mL) and a 30% hydrogen peroxide solution (20 mL) were used per 10 g of dry biomass supplemented with 50 mL of water. In addition, 2 mL of sulfuric acid (H2SO4) was added to the reaction mixture as a catalyst. The mixture was heated at 60 °C for an hour with constant stirring. As a result, fibers were obtained, which were separated by filtration and washed with distilled water.
2.3. MALDI-TOFMethod
The process of optimizing the delignification conditions, and the procedure for the physicochemical analysis of the reaction products, was carried out according to the technique described in [
22]. For this, the MALDI-TOF method was used. The MALDI-TOF method is based on the procedure of soft ionization of the test material (analyte), which allows, in the presence of a special substance, the so-called matrix, under the influence of a laser to ionize biological macromolecules (peptides, proteins, DNA, oligonucleotides, lipopolysaccharides, and sugars) without their fragmentation and destruction. The most widely used matrix is α-cyano-4-hydroxycinnamic acid (CHCA), sinapinic acid (SA), ferulic acid (FA), and 2,5-dihydroxybenzoic acid (DHB). After the laser beam ionization, the system scans for microbial proteins, which generally fall in the range of 4000 to 20,000 Da (60 to 70% of the dry weight of the bacterial cell). After desorption, predominantly single-charged ionized molecules are accelerated in an electric field, enter the separating part of the device (a tube in the cavity of which a vacuum is maintained), after passing through which the ions reach the detector. The speed of movement and, accordingly, the time it takes to travel from the point of ionization to the detector, is inversely proportional to the mass of the ions. Knowing the path length of ion movement from the ionizer to the detector, as well as the time of this movement, it is possible to calculate the speed of ion movement and, based on its value, calculate the mass of particles present in the analyte, as well as generate a spectrum characterizing the qualitative composition of the object under study [
25].
2.4. Induced Mutagenesis of Microorganisms
The studied microorganisms were consistently subjected to physical and chemical mutagenic effects to enhance their cellulolytic properties. The technique used to induce mutagenesis is described hereafter and was created based on those presented in [
20,
26,
27,
28,
29,
30] and adapted to the existing conditions.
Physical mutagenesis was carried out in the microbiological safety cabinet BMB-II- Laminar-S-1.2 (221.120) Class II (Type A2) using a Philips TUV 30W G13 ultraviolet lamp (LAMSYSTEMS, Mias, Russia) with maximum radiation at253.7 nm. A suspension based on sodium phosphate buffer (pH 7.0) at a concentration of 108 spores/mL was prepared from a 5-day culture of microorganisms. A quantity of 2 mL of the resulting suspension was placed on a Petri dish with a nutrient medium. The medium contained the following (g/L): 0.3 urea, 1.4 (NH4)2SO4, 2.0 KH2PO4, 0.4 CaCl2·2H2O, 0.3 MgSO4·7H2O, 1.0 peptone, 0.2 Tween 80, 0.005 FeSO4·7H2O, 0.0016 MnSO4·7H2O, 0.0014 ZnSO4·7H2O, 0.02 CoCl2·6H2O, 10.0 cellulose; pH 5.
Then, the cups were positioned at a distance of 10–13 cm from the UV lamp. The exposure time varied from 45 to 120 min, after which the dishes were incubated in the dark at 30 °C for three days. The spore solution was prepared as follows: A suspension was prepared from a 3-day culture of microorganisms based on sodium phosphate buffer (pH 7.0) and a concentration of 108 spores/mL. The resulting suspension was mixed with a solution of sodium azide/ethidium bromide in ratios of 9:1 and 1:1. The concentration of sodium azide in the solution was 5 and 400 mg/mL, ethidium bromide 5 and 150 mg/mL, respectively. After exposure for 30 and 80 min at room temperature, the spores were washed three times with sterile deionized water. The supernatant was removed after 15 min of centrifugation at 6000× g. Spores were resuspended in sodium phosphate buffer and transferred to plates with a nutrient medium. They were incubated for 5 days, after which the cellulolytic activity was checked and the most effective colonies were selected for subsequent studies. A spore suspension was washed with 0.05 M citrate buffer (pH = 4.8) from a plate with a 5-day culture.
Spore concentration was determined using a Hirst volumetric impaction sampler (General Electric Company plc, Borehamwood, UK). The spores fixed on the strip were examined using a light microscope. Ten fields of view were selected and the number of spores was counted on the strip segment corresponding to a 3-h log.
Chemical mutagenesis was performed as described above using the sole sodium azide and ethidium bromide treatment. Spores were resuspended in sodium phosphate buffer and transferred onto plates with a nutrient medium. Spores were incubated for 5 days, followed by a verification of cellulolytic activity and the selection of the most effective colonies for subsequent studies.
2.5. CellulolyticActivities Measurement
Cellulase activity was determined using an enzymatic assay.
The Bradford method [
31] was used to obtain the protein concentration. This method is based on the shift of the absorption maximum of the optical density of the acid blue 90 (Coomassie Brilliant Blue R-250) dye from 470 to 595 nm, observed due to the binding of the protein to the dye.
The enzymatic activity of the preparation was determined in comparison with a standard sample (SS) of this enzyme under the same experimental conditions. The enzymatic activity (EA) in the appropriate units (IU or U) was calculated by the following formula [
32]:
where
A0—SS enzymatic activity is in units (IU or U) per 1 g of protein or preparation;
P0—value of the measured parameter for SS;
p—value of the measured parameter for the test preparation;
C—coefficient equalizing the concentrations of solutions of the test preparation and SS.
Enzyme activity is expressed in international units IU (or U) and is equal to the amount of enzyme that catalyzes the conversion of 1 μM of reducing sugars (glucose equivalent) in 1 min at 50 °C.
2.6. Aspergillus Niger Growth Parameters and Determination of the Concentration of Spores in Suspension
The protocol used for the enzymatic hydrolysis is an adaptation of the hydrolysis techniques described in the literature [
32,
33]. Enzymatic hydrolysis was carried out in 1 and 0.25 L conical flasks with cotton and gauze plugs with a working volume of 200 and 50 mL, respectively. The flasks were closed with plastic stoppers and periodically stirred in an IKA KS4000I control incubator shaker (DV-Ekspert, Moscow, Russia). Stirring trajectory was orbital. Torque range was from 10 to 500 rpm. The reaction was carried out under static conditions at a temperature of 30–37 °C for 3–7 days. The substrate concentration in all samples was 60 g/L. The inoculum concentration varied from 10
6 to 10
8 spores/mL. The growth curve of
A. niger during cultivation is shown in
Figure 1. The strains were grown at a temperature of 27–30 °C.
The concentration of the spore suspension was obtained measuring A600 Smart Spec Plus spectrophotometer (BioRad Laboratories Inc., Hercules, CA, USA) (r = 0.63). Enzymatic activity was interrupted by heating in an autoclave to 121 °C without standing.
2.7. Optimization of Conditions for Enzymatic Hydrolysis
Original and treated strains were cultivated under the same conditions. To optimize the parameters of enzymatic hydrolysis, the cellulase activity of treated and original strains of
Aspergillus niger were studied at temperatures of 30, 37, and 50 °C. The enzymatic activity of original and treated microorganisms was compared at these temperatures. The influence of the composition of the nutrient medium, on which the microorganism culture (UV microorganism) was incubated, on the cellulolytic activity during hydrolysis was assessed. For this purpose, microorganisms were inoculated in malt-peptone agar, Czapek–Dox medium, Mandels–Weber saline medium, and potato agar [
18]. These media were used because they are standard nutrient media for the cultivation of microorganisms (in particular, fungi), contain all the necessary nutrient components (sources of sodium, potassium, magnesium, iron, agar, peptone, sucrose, and other nutrient components), have optimal pH for the development of microorganisms. They are easy to prepare and convenient to use.
The hydrolysis duration was 1 h and 48 h. To optimize the enzymatic hydrolysis parameters, the total cellulolytic activity level of all studied strains was determined relative to the following different compositions of raw materials: filter paper, recycled cellulose-containing raw materials, secondary starch-containing raw materials (fruit waste, potato starch), miscanthus cellulose after alkaline pretreatment, miscanthus cellulose after acid pretreatment and cellulose. Small substandard fruit products affected by pests (a mixture of apricots and prunes 1:1) were used as substrates (fruit waste) for enzymatic hydrolysis. Fruits were ground using a KT-1321 laboratory grinder (Profit, Moscow, Russia). Potato starch was obtained by processing substandard, non-standard small potatoes, as described in [
34].
2.8. Method for the Analysis of Hydrolysis Products
The content of reducing substance in the sample was determined using the reagent 3,5-dinitrosalicylic acid (DNS) according to the method described in GOST R 54905-2012 (Enzyme preparation. Methods of beta-glucanase enzyme activity determination), which allows determining the total amount of reducing sugars (in our studies it was glucose) [
35,
36]. Glucose is the most important reducing substance in hydrolyzed cellulose samples.
A solution of 1% DNS per 1 L was prepared by dissolving 10 g of DNS in a small amount of water at room temperature and the subsequent gradual addition of 16.05 g of sodium hydroxide and 300 g of potassium–sodium tartrate (in a water bath at 47 ± 1 °C, “soft” cooling that does not destroy the molecules of substances). The reagents were purchased from Pushchinskie Laboratorii (Moscow, Russia). The resulting solution had a bright yellow color. To construct a calibration graph, a stock solution of D-glucose (1 µmol/mL) and a series of its dilutions (0.3–0.6 µmol/mL) were prepared based on citrate or acetate buffer, depending on the medium in which the hydrolysis was carried out. Before analysis, the DNS solution was measured on a spectrophotometer to clarify the absorption maximum. The obtained value (530 nm) was slightly lower than that indicated in GOST (540 nm). To assess the content of the reducing substance, and to build a calibration curve, a 2 mL solution of DNS was thoroughly mixed with 1 mL of the sample and heated in a water bath for 5 min with an accuracy of a few seconds. After cooling, the sample volume was brought to 25 mL with buffer and analyzed on a Shimadzu UV-1800 spectrophotometer (Shimadzu, Kyoto, Japan) at a wavelength of 530 nm in cuvettes with a 10 mm light-absorbing layer.
2.9. Statistical Analysis Methods
Statistical processing was performed using Excel (2019, Microsoft, Redmond, Washington, USA) and IBM SPSS Statistics 22 (2013, SPSS: An IBM Company, Chicago, IL, USA). All experiments were carried out in triplicate. Data are presented as the median ± standard deviation. The Kruskal–Wallis test was used to compare the medians of the samples (significance of differences at p < 0.05). For intergroup comparisons, the Mann–Whitney U-test was used with the Bonferroni correction (significance of differences at p < 0.01). To check for the presence of a correlation between the UV exposure time and quantitative indicators of cellulolytic activity, the Spearman’s rank correlation coefficient was used (significance of differences at p < 0.05).
4. Discussion
In the first stage of this study, the cellulolytic activity of the original
A. niger strain was assessed in relation to six insoluble substrates, one of which being the model (filter paper). It was found that citrate buffer, with a concentration of 50 mM, was more suitable for enzymatic hydrolysis, and the advantage was noticeable after 48 h of hydrolysis (
Table 1). The hydrolysis conditions were as follows: stationary, 30 °C, and pH = 4.7. The recommended substrate (filter paper) concentration for hydrolysis is 50 mg/L. With a further increase in the concentration of the substrate, the formation of the reducing substance decreased. The relatively low degree of hydrolysis (
Table 1) is explained by the endothermicity of this process. The degree of hydrolysis increased concomitantly with the increasein temperature, and the equilibrium shiftedtowards the hydrolysis products formation, as confirmed by the data in
Table 3.
When using acetate buffer as a medium for the hydrolysis process, the yield of the reducing substance was slightly higher in comparison with that of the citrate buffer. However, when a suspension of microorganisms was added to the acetate buffer, the yield of the reducing substance dropped. It is likely that the acetate buffer inhibited the functioning of the microorganisms. In addition, it was noted [
32] that the acetate buffer is able to suppress the enzymatic activity of microorganisms, which can adversely affect further use of the hydrolysate under alcoholic fermentation.
When comparing the cellulase activity of
A. niger with non-model substrates (
Table 2), it was found that the maximum conversion of cellulose into reducing sugars was observed when using miscanthus cellulose (with alkaline pretreatment), and the minimum one was observed using wood chips. The hydrolysis conditions were as follows: stationary, 37 °C, and pH = 4.7.
As a result of the first stage, it was revealed that the studied original strain exhibited stable, but low, cellulase activity. Our results agree with the data that are available in the literature. Thus, in foreign studies in this area, it is customary to use either directed genetically treated microorganisms or commercial enzyme preparations. In Russian studies, it is customary to use commercial enzyme preparations. Within the framework of this study, a decision was made to activate cellulase activity by physicochemical action, and also to optimize the enzymatic hydrolysis. The expected results were obtained, which confirms the adequacy of the functioning of a commercial enzyme preparation; an increase in cellulolytic activity, with an increase in the dose of the preparation, and with an increase in the temperature of the hydrolysis. Our results allow for the correlation of the level of enzymatic activity in the studied microorganisms, with cultivation conditions. The hydrolysis conditions were as follows: stationary, 37 °C, and pH = 4.7. The filter paper was hydrolyzed according to a commercial enzyme dosage of 50 mg/L. The obtained data are consistent with the dosages and units of the commercial enzyme for all types of cellulose-containing raw materials.
A qualitative reaction, using a Congo red solution (
Figure 3), showed an increase in the cellulolytic activity of the treated
A. niger samples, by increasing the radius of the light spot around the colony (the dye reacts with glucose obtained from the cleavage of cellulose contained in the medium). A variant of the medium without the addition of simple carbohydrates was used for verification purposes.
A quantitative assessment of the enzymatic activity of the mutant strains also showed a positive result (
Table 4). The obtained data are consistent with the dosages and units of the commercial enzyme for all types of cellulose-containing raw materials.
After mutagenic action, the spore suspension was separated and partly cultivated on a nutrient medium containing cellulose, and partly on a medium containing potato waste. The total cellulase activity of the first passage was maximal in the cultures that were exposed to UV treatment for two hours; as the UV exposure time increased to two hours, the cellulase activity of the surviving part of the culture increased (r = 0.706; p < 0.05).
The studied temperature range was limited from 30 to 50 °C. With respect to secondary raw materials, enzymatic hydrolysis using treated strains was more efficient at 37 °C, whereas miscanthus cellulose and wood chips were more efficiently hydrolyzed at 50 °C. The obtained data are consistent with the literature [
26,
34,
38,
39,
40,
41,
42,
43,
44]. In these studies, the highest enzymatic activity of the relative secondary raw materials was found in the UV strain (92.3 IU/h or 1.5 IU/min).
Comparatively, similar data were obtained in [
26], in which the cellulase activity of
A. niger during the hydrolysis of fruit wastes was 64.5 IU. Zao et al. [
43] showed an increase in enzymatic activity with the combined use of recombinant
A. niger and
T. reesei, up to 12 IU. In a study by Abdullah et al. [
44], the cellulase activity of UV-treated
Bacillus sp. increased to 11 IU compared to the control (7.5 IU).
The enzymatic activity of the strains that were obtained in this work, relative to the primary raw material (miscanthus cellulose and wood chips), and filter paper in some cases, was inferior to that of the commercial enzyme preparation (8.6 versus 9.1 IU in the hydrolysis of filter paper, for example). However, it was possible to increase the total cellulase activity in the case of joint use.
During the fermentation of miscanthus cellulose (
Table 8) in an acidic medium,
A. niger UV120 + CH30, obtained by us, exhibited a greater enzymatic activity than the microorganisms that have been presented in other studies [
43,
44]. However, during the hydrolysis of fruit waste and wood chips, it was possible to achieve a greater enzymatic activity of
A. niger.
The results of the enzymatic activity of the samples vary significantly (
Table 8). However, they prove the possibility of obtaining an enzyme that breaks down cellulose of various origins, and the very fact of this enzymatic cleavage. The variation in the parameters is explained by the difference in the microorganisms producing the enzyme, and the conditions of enzymatic hydrolysis (different temperature, time, pH of the process) [
26,
34,
38,
39,
40,
41,
42,
43,
44].
The results of the study favor the use of the PA and M-W media, in addition to a more acidic medium (pH = 4.4). A higher enzymatic activity of cellulases inthe mutated A. niger, compared to the original strain, was shown. When using the A. niger UV strain, the highest yield of the reducing substance was observed when using secondary starch-containing raw materials, at both 37 and 50 °C. It is more expedient to carry out enzymatic hydrolysis of the wood chips and cellulose of miscanthus using a UV strain at a temperature of 50 °C.
In this case, miscanthus cellulose after alkaline pretreatment was more exposed to degradation. The CH strain exhibited a cellulolytic activity with less deviation from the mean relative to the type of substrate used. The activity of this strain was not statistically significant relative to the hydrolysis temperature, except for the case in which the substrate was miscanthus cellulose after acid pretreatment.
The model substrate (filter paper) and wood chips were the least susceptible to enzymatic degradation under the influence of the cellulolytic complex, by both UV and CH strains of A. niger.
5. Conclusions
A number of stages were undertaken in this research, as follows: the pretreatment of various cellulose-containing raw materials was carried out, the cellulolytic activity of microorganisms was studied, physicochemical undirected mutagenesis of microorganisms was conducted to intensify the enzymatic activity, and the optimal conditions for the enzymatic hydrolysis of filter paper, secondary cellulose-containing raw materials, secondary starch-containing raw materials, miscanthus cellulose after alkaline pretreatment, miscanthus cellulose after acid pretreatment, and wood chip cellulose, were selected. As a result, the treated strains of Aspergillus niger, with an increased ability to break down cellulose and starch, were obtained. The analysis of the hydrolysis parameters was carried out to identify the recommended conditions, as follows: hydromodule 1:20, temperature 37 °C. To obtain a higher yield of RA for the cultivation of microorganisms, a Mandels–Weber salt medium should be used for the further hydrolysis of the cellulose-containing substrate, and a PA medium for the hydrolysis of starch-containing raw materials. A quantity of 0.05 M citrate buffer with pH 4.4 is more suitable as a medium for enzymatic hydrolysis.
Our future research will focus on the intensification of the process of enzymatic hydrolysate production for subsequent alcoholic fermentation. However, there are numerous potential applications of fermented cellulose. Some studies [
45,
46] showed that fermented celluloses are a vivid example of natural sources of innovative technologies for use in materials science and biotechnology. A variation in the applications exists for nanocellulose (from mass-produced industrial goods to high-quality medical products).
Research teams are actively working to globally expand the range of nanocellulose products, and find entirely new areas of application [
8,
46,
47,
48]. It has been established that microbial cellulose is an extremely versatile biomaterial that can be used in a wide variety of applied scientific purposes, such as paper products, electronics, acoustics, and biomedical devices. Biomedical devices have recently received a large amount of attention due to an increased interest in tissue products for wound care, and the regeneration of damaged or diseased organs. Due to its unique nanostructure and properties, microbial cellulose is a natural candidate for numerous applications in medicine and tissue engineering. The microbial cellulose membrane can be successfully used as a wound-healing device for severely damaged skin, and for replacing small-diameter blood vessels. Microbial cellulose microfibril nonwoven ribbons strongly resemble the structure of native extracellular matrices, suggesting that they can function as a scaffold for the production of many tissue-engineered structures. In addition, microbial cellulose membranes with a unique nanostructure have many other uses in wound healing and regenerative medicine, for example, in guided tissue regeneration, the treatment of periodontitis, or as a replacement for the dura mater (the membrane that surrounds brain tissue). Microbial cellulose can function as a scaffold for the regeneration of a wide variety of tissues, showing that it could ultimately become an excellent technological platform for medicine.